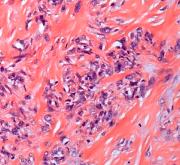

纤维肉瘤

【例例生辉】手臂上的色素斑块多年没变化,别大意,可能是罕见肿瘤!
学术进展
2025-05-04

儿童肿瘤治疗新星闪耀,NTRK基因融合精准治疗开启新篇章
学术进展
2024-07-04

燃爆7月 | 临床大碰撞,NTRK基因融合泛肿瘤病例研讨会
学术进展
2023-07-19

Nrf2信号通路在肠缺血再灌注损伤中作用机制的研究进展
学术进展
2023-05-18
应用机器人导航结合3D打印个性化假体治疗小腿黏液纤维肉瘤一例
病例
2025-10-29
应用机器人导航结合 3D 打印个性化假体治疗小腿黏液纤维肉瘤一例
病例
2025-10-19

乙状结肠系膜黏液纤维肉瘤1例
病例
2025-02-25

胃上皮样黏液纤维肉瘤1例
病例
2024-03-27

NCCN临床实践指南:隆突性皮肤纤维肉瘤(2026.V2)
指南
2025-10-28
NCCN临床实践指南:隆突性皮肤纤维肉瘤(2026.V1)
指南
2025-09-09
2024 欧洲跨学科共识指南:隆凸性皮肤纤维肉瘤的诊断和治疗(更新版)
指南
2025-02-07
NCCN临床实践指南:隆突性皮肤纤维肉瘤(2025.V1)
指南
2024-10-13
甲磺酸伊马替尼胶囊
-用于治疗费城染色体阳性的慢性髓性白血病(Ph+CML)的慢性期、加速期或急变期;-用于治疗不能切除
甲磺酸伊马替尼胶囊
用于治疗费城染色体阳性的慢性髓性白血病(Ph+CML)的慢性期、加速期货急变期。用于以下适应症的安全
甲磺酸伊马替尼片
-用于治疗费城染色体阳性的慢性髓性白血病(Ph+CML)的慢性期、加速期或急变期;-用于治疗不能切除